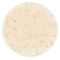
mini photo

入数 1箱 販売価格 ¥10,345 (税込)
キッコーマンバイオ
【冷蔵】Easy Plate 一般生菌数迅速測定用(25枚/袋×4袋入)AC−R
【A04F-5318】



3/2(月)〜 3/31(火)
| ¥10,345 (税込) / ¥9,405 (税抜) |
| ¥10,345 (税込) / ¥9,405 (税抜) |
| メーカー希望小売価格※税抜 (割引率) ¥11,000(14%) |
|---|
培地関連用品の売れ筋ランキング
- ¥3,135(税込) (税込) 〜
- ¥10,971(税込) (税込) 〜
- ¥6,030(税込) (税込)
- ¥3,135(税込) (税込)
- ¥2,090(税込) (税込)
商品の特徴 |
粉末培地の調製や事前のオートクレーブ滅菌が不要で、不意の検査にもすぐに対応できます。混釈・重層の必要がなく、作業時間も短縮可能です。一般生菌のコロニーを明瞭な赤色に発色させ、検出するフィルム培地です。 |
|---|---|
商品仕様 |
|
メーカー情報 |
|
カタログ掲載ページ |
-/- |
| 注意事項 | ※この商品は貯蔵または配送の際に冷蔵必要な商品です。【お届けに関するご注意】この商品は、画面に表示されているお届け予定日までにお届けいたします。実際のお届けが、予定日よりも早まる場合がございます。 |
|---|